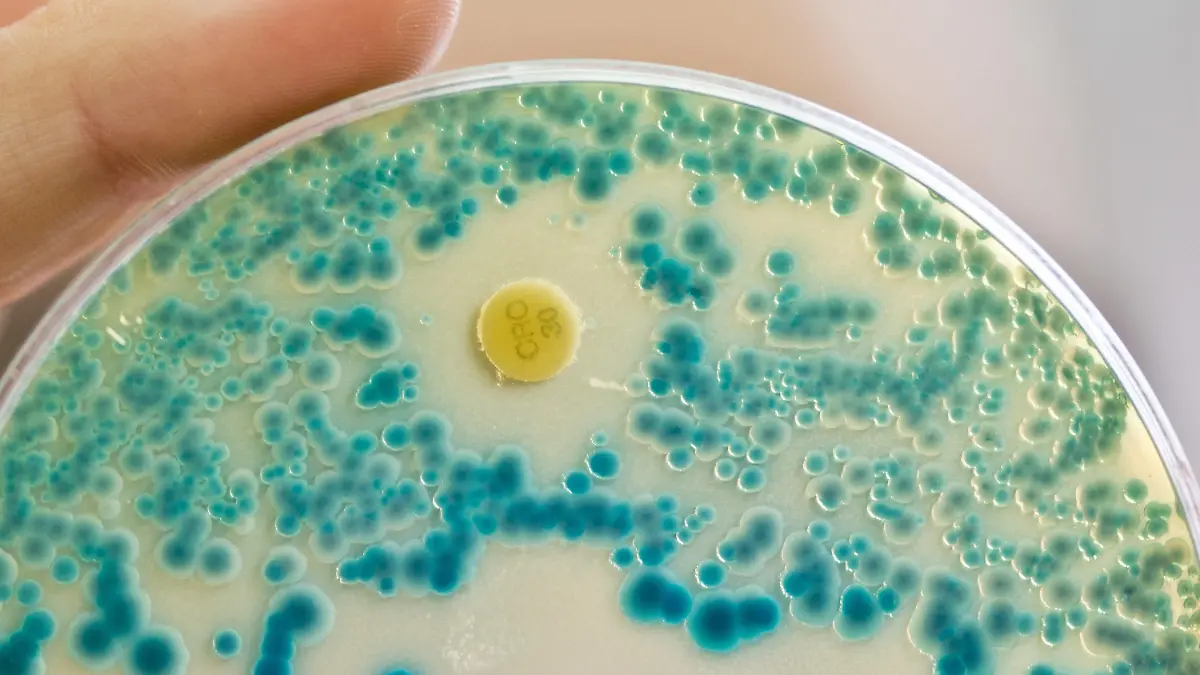

Welcher Arten gibt es?Gesundheitslexikon: Indikator
Aus dem Sprachgebrauch werden Indikatoren in der Regel als Hinweise verstanden. Tatsächlich leitet sich das Wort vom lateinischen Verb "indicare" für "anzeigen" ab und steht in der Umgangssprache für sämtliche Anzeichen, die ein bestimmtes Ereignis andeuten. In der Chemie sind Indikatoren Informationsanzeiger, die zur Feststellung von Zuständen und chemischen Reaktionen eingesetzt werden. Auch in der Medizin kommen hinter den Kulissen in Laboren chemische Indikatoren zum Einsatz, die dem Arzt bei der Diagnostik behilflich sind und Hinweise auf krankhafte Körperzustände geben. Neben chemischen Indikatoren nutzt die medizinische Diagnostik auch weitere Indikatorarten für den diagnostischen Bereich.
Definition: Was sind Indikatoren in der Medizin?
Jeder medizinische Indikator entspricht einer Substanz, die eine sichtbare oder anderweitig messbare Veränderung durchmacht und dadurch bestimmte Vorgänge oder Zustände anzeigt. Der Einsatzbereich von Indikatoren liegt dabei vorwiegend in der Diagnostik. Außerdem dienen Indikatoren zur Abgrenzung von aktiven Organbereichen und der Eruierung von Shuntvolumina. Shunts sind dabei Kurzschlussverbindungen, die einen Flüssigkeitsübertritt zwischen eigentlich voneinander getrennten Hohlräumen zulassen, so beispielsweise von Gefäßen. Sowohl für therapeutisch angelegte Shuntvolumina, als auch zur Bestimmung eines fehlbildungsbedingten Shuntvolumens kommen Indikatoren zum Einsatz. Ein Beispiel für solche Indikatoreinsätze ist der Nachweis von Glukose innerhalb des Urins.
Formen: Welche Arten von medizinischen Indikatoren gibt es?
Medizinische Indikatoren sind, anders als chemische Indikatoren, nicht auf den Nachweis chemischer Reaktionen begrenzt. Zum Einsatz kommen unterschiedlichste Indikationstechniken, so vor allem
pH-Indikatoren, die mit Farbveränderungen abnorme pH-Werte anzeigen und in ihrem Funktionsprinzip chemischen Indikatoren folgen.
Enzymindikatoren, die mit einer enzymatischen Reaktion auf eine bestimmte Substanz reagieren und damit den Substanznachweis erlauben.
radioaktive Indikatoren in Form von radioaktiv markierten Substanzen, die sich in bestimmten Regionen des Körpers anreichern und in der MRT-Bildgebung bestimmte Strukturen sichtbar machen.
Lichtabsorbierende und emittierende Substanzen, die eine Elimination verursachen und ohne invasive Methoden messbar sind, so beispielsweise in Form von Indocyaningrün.
Funktionsprinzip: Wie funktionieren diagnostische Indikatoren?
Das Funktionsprinzip von Indikatoren hängt von der Indikatorart ab. PH-Indikatoren ermitteln den pH-Wert bestimmter Stoffe und zeigen diesen über Einfärbungen an. Über eine Farbskala lässt sich das Ergebnis ablesen. Neben Lackmus werden für pH-Indikatoren Bromthymolblau und Phenolphthalein, das seine Farbe jedoch nur nach Zugabe alkalischer Lösungen ändert, verwendet. Für genaue pH-Wertmessungen kommen oft Universalindikatoren zum Einsatz, die über eine Papierstreifenfärbung saure, alkalische oder neutrale Lösungen anzeigen. pH-Indikatoren zeigen grundsätzlich Unterschiede im Umschlagbereich im Sinne des pH-Bereichs, ab dem der Wechsel zwischen den angezeigten Farben stattfindet. Ähnliche Prinzipien wie pH-Indikatoren verfolgen Schwangerschaftstests, deren Teststreifen sich abhängig vom Hcg-Gehalt verfärben.
Anwendungsbereiche: Wo verwendet die Medizin sonst noch Indikatoren?
Obwohl der Haupteinsatzbereich medizinischer Indikatoren die Diagnostik ist, kommen die Testsubstanzen auch in einem anderen wichtigen Feld zum Einsatz: zur Prüfung der Sterilität. Bei der Funktionskontrolle medizinischer Sterilisatoren zeigen Papierstreifen mit chemischen Substanzen unter keimabtötenden Bedingungen Verfärbungen. Die Sterilisationskontrolle ist ein lebenswichtiges Gebiet. Deshalb sind chemische Indikatoren wegen ihrer methodisch bedingten Ungenauigkeit im Hinblick auf die Keimfreiheitskontrolle als alleinige Indikation zu ungenau. Zusätzlich finden hier auch biologische Indikatoren in Sporenform zur halbjährlichen Funktionskontrolle der Sterilisatoren Verwendung.